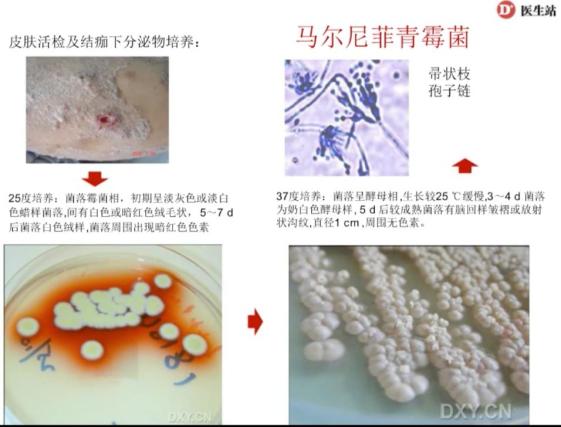

- +1
老年人超30处关节肿痛,你只会想到类风湿关节炎吗?
原创 穿背带裤的水管工 医学界风湿免疫频道
来试试你的火眼金睛!
之前发布的病例合集《》推出后,小编收到了很多读者的留言。
 不知道大家对这些特殊病例掌握了多少呢?小编可还意犹未尽呢,这波大开眼界是真的不亏!
不知道大家对这些特殊病例掌握了多少呢?小编可还意犹未尽呢,这波大开眼界是真的不亏!这不,小编又从苏茵主任的讲课中get到了3个风湿免疫科的特殊病例。一起来看看,你能诊断出几个?
01
多关节受累
我们先看一个病例练练手!患者双手多关节肿痛,给人第一印象肯定是类风湿关节炎,但多关节肿痛累及超30处的患者你见过吗?
病例特点:患者男性,69岁,4年前左手MCP2肿痛,局部皮肤发红,通过10天左右的治疗后好转;同年年底,患者双踝、足MTP1-3肿痛,皮肤发红,治疗半个月后好转。5个月前患者双手MCP、PIP、腕关节肿痛,双肩关节上举困难,症状持续,时轻时重,并出现晨僵,持续30分钟左右。
近来,患者右手PIP3出现白色结节,破溃后流出白色分泌物,遂就医。10天前,患者出现右膝关节肿痛,疼痛剧烈,伴局部红肿热痛,体温曾达38度。
 图1:体格检查和实验室检查结果
图1:体格检查和实验室检查结果 图2:红色部分为患者的多关节受累
图2:红色部分为患者的多关节受累苏茵主任表示,如果按2010年类风湿关节炎诊断标准,患者仅关节肿痛,再加上血沉和C反应蛋白的指标,评分为8分;评分大于6分,就可以诊断为类风湿关节炎。那么,这个患者真的是类风湿关节炎吗?
下面,我们一起来看一下该患者的关节表现。
 图3:患者手关节、膝关节和脚关节的变化
图3:患者手关节、膝关节和脚关节的变化 图4:影像学检查
图4:影像学检查苏茵主任提示,虽然我们能够从11年到14年的影像学资料上看到,该患者近端指间关节处有明显的关节破坏,但这种破坏跟我们以往看到类风湿关节炎的虫噬样改变是不一样的。
 图5:患者MRI表现,无骨端骨质舒松,与常见的类风湿关节炎不同
图5:患者MRI表现,无骨端骨质舒松,与常见的类风湿关节炎不同患者的影像学表现均与以往类风湿关节炎的常见表现不同,又对患者进行了超声检查。
 图6:腕关节内可见点状高回声
图6:腕关节内可见点状高回声 图7:掌指关节软骨表面可见线状高回声,提示“双轨征”
图7:掌指关节软骨表面可见线状高回声,提示“双轨征”苏茵主任指出,在关节超声表现下出现“双轨征”提示“尿酸盐的结晶”。
看到这里,答案呼之欲出了,你的诊断是?
想不出来先别急!继续往下走,看完下面两个特殊病例的诊断结果后,小伙伴们一定能打开思维,再回顾这个病例你一定就有答案啦~
02
美女面目全非
这是一位青年女性,患有全身型银屑病12年,一直服用中药。3个月来皮疹加重,间断发热,体温最高38.6度;1个月来皮疹进行性加重,低热,食欲减退、体重减轻,仍坚持服用中药。
查体发现,患者一般状况差,全身散在分布疣状结节,直径1-2cm不等,突出皮面,部分破溃,有血性分泌物,部分结痂;头部满布银屑样斑疹,全身浅表淋巴结肿大、固定、质硬,直径1-3cm不等,部分粘连;口腔附着厚灰白色伪膜,黏膜充血、糜烂。
 图8:全身散在分布疣状结节
图8:全身散在分布疣状结节 图9:辅助检查结果
图9:辅助检查结果银屑病的典型症状是出现界限清楚的红斑上面覆盖着银白色的鳞屑,但像这位患者这样全身散在分布疣状结节,苏茵主任表示,工作这么多年,还是第一次见。
那么,导致美女面目全非的“罪魁祸首”会是银屑病吗?从皮肤活检及结痂下分泌物的培养中或许能找到答案……
图10:皮肤活检及结痂下分泌物培养出马尔尼菲青霉菌
图10:皮肤活检及结痂下分泌物培养出马尔尼菲青霉菌看到这里,你认为患者最可能的诊断是什么?
 左右滑动查看答案
左右滑动查看答案问题来了,什么是马尔尼菲青霉菌呢?
苏茵主任指出,马尔尼菲青霉菌为一种条件致病菌,机体抵抗力低下的患者发病。多由皮肤和呼吸道感染,可以全身播散,也可以局限,主要表现为皮肤疣状结节,90%发生在HIV感染患者。
最终,谜底揭开,1周后复查患者HIV阳性。
03
18岁少女步态异常
这是一位18岁少女,5年前,双膝、髋关节疼痛,伴膝关节肿胀及活动受限,无晨僵;3年前,累及双手近端指间关节;2年前症状逐渐加重,双踝、双肘关节疼痛及活动受限,无肿胀,双膝双髋疼痛加重,无晨僵。
这样看,这位患者的临床表现是不是跟类风湿关节炎十分相似?
再来看看患者的既往史,自幼双手近端指间关节粗大、远端指间关节屈曲畸形,不影响活动;自幼步态异常,但13岁以前体育活动可正常进行。查体,患者身高150cm,摇摆步态,胸廓畸形。
 图11:查体
图11:查体来看患者的X线检查。
 图12:者双手X线检查
图12:者双手X线检查 图13:患者双髋X线检查
图13:患者双髋X线检查看到这里,你的诊断是?
 左右滑动查看答案
左右滑动查看答案苏茵主任指出,进行性假性类风湿发育不良症的临床表现类似类风湿关节炎,但x线片显示进行性假性类风湿发育不良症患者全身骨及软骨发育不良。
 图14:进行性假性类风湿发育不良症的特点
图14:进行性假性类风湿发育不良症的特点最后,苏茵主任强调,作为一个内科医生,在临床上,要多问几个为什么,才能给患者做出一个良好的诊断。如果发现疑难病例,临床上不能用常规的办法去解释症状时,不仅要考虑自身免疫病的可能,也要考虑有没有特殊类型的感染、肿瘤或者其他代谢性疾病,还有一些近年来新兴疾病的可能。
本文整理自“医学界医生站”在线视频课程,由北京大学人民医院风湿免疫科苏茵主任讲授,欲知完整版课程内容,请登录医生站APP观看。
本文首发:医学界风湿与肾病频道
本文作者:穿背带裤的水管工
本文审核:陈新鹏 副主任医师
责任编辑:芋子
"医学界"力求所发表内容专业、可靠,但不对内容的准确性做出承诺;请相关各方在采用或以此作为决策依据时另行核查。
原标题:《老年人超30处关节肿痛,你只会想到类风湿关节炎吗?》
本文为澎湃号作者或机构在澎湃新闻上传并发布,仅代表该作者或机构观点,不代表澎湃新闻的观点或立场,澎湃新闻仅提供信息发布平台。申请澎湃号请用电脑访问http://renzheng.thepaper.cn。





- 报料热线: 021-962866
- 报料邮箱: news@thepaper.cn
互联网新闻信息服务许可证:31120170006
增值电信业务经营许可证:沪B2-2017116
© 2014-2026 上海东方报业有限公司




